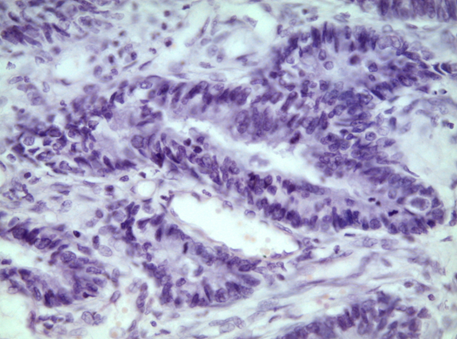

Другое: Микропрепараты к практическому занятию. Учение об опухолях. Эпителиальные опухоли
Описание
МИКРОПРЕПАРАТЫ К ПРАКТИЧЕСКОМУ ЗАНЯТИЮ "УЧЕНИЕ ОБ ОПУХОЛЯХ. ЭПИТЕЛИАЛЬНЫЕ ОПУХОЛИ"
Препарат № 100.
АДЕНОКАРЦИНОМА ТОЛСТОЙ КИШКИ
Окраска: гематоксилин-эозин
В одной части препарата обнаруживаем нормальное строение слизистой оболочки. На большем протяжении слизистая представлена опухолевой тканью, паренхима ее состоит из причудливых ветвящихся железистых трубочек, эпителий которых полиморфный; ядра крупные, сочные, гиперхромные с множеством митозов. Такие же железистые образования видны в подслизистом и мышечном слоях стенки. В строме опухоли воспалительные инфильтраты, очаговые кровоизлияния.


Препарат № 139.
ПЛОСКОКЛЕТОЧНЫЙ ОРОГОВЕВАЮЩИЙ РАК (ПИЩЕВОДА)
Окраска: гематоксилин-эозин
Пласты и тяжи атипичного плоского эпителия врастают в подлежащую соединительную ткань и в мышечную оболочку пищевода. В центре пластов происходит ороговение эпителия – образуются так называемые «раковые жемчужины». В строме опухоли инфильтрация преимущественно лейкоцитами и плазматическими клетками. Обратить внимание, что в имеющихся в препарате небольших лимфоузлах метастазов еще нет.
Отметить:
1. Атипичные эпителиальные пласты
2. Лимфоузел
3. «Раковые жемчужины».


Препарат № 380.
МЕТАСТАЗ МУЦИНОЗНОЙ АДЕНОКАРЦИНОМЫ В ЛЕГКОЕ
Окраска: гематоксилин-эозин
В ткани легкого – опухолевый узел слизеобразующей (муцинозной) аденокарциномы.
Отметить:
1. Метастаз аденокарциномы
2. Слизь.


Препарат № 381
АДЕНОКАРЦИНОМА В ВОРСИНЧАТОЙ АДЕНОМЕ ТОЛСТОЙ КИШКИ
Окраска: гематоксилин-эозин
Полиповидное опухолевое образование толстого кишечника из пролиферирующего железистого эпителия с признаками дисплазии, покрывающего ворсинчатые выросты – аденома. В опухоли определяются очаги инвазивной внутрислизистой аденокарциномы в виде плохо сформированных сливающихся железистых комплексов из атипичного эпителия. В крае препарата сохранена нормальная слизистая толстой кишки.
Отметить:
1. Ворсинчатая аденома
2. Аденокарцинома
3. Нормальная слизистая.



СГМУ
Spes